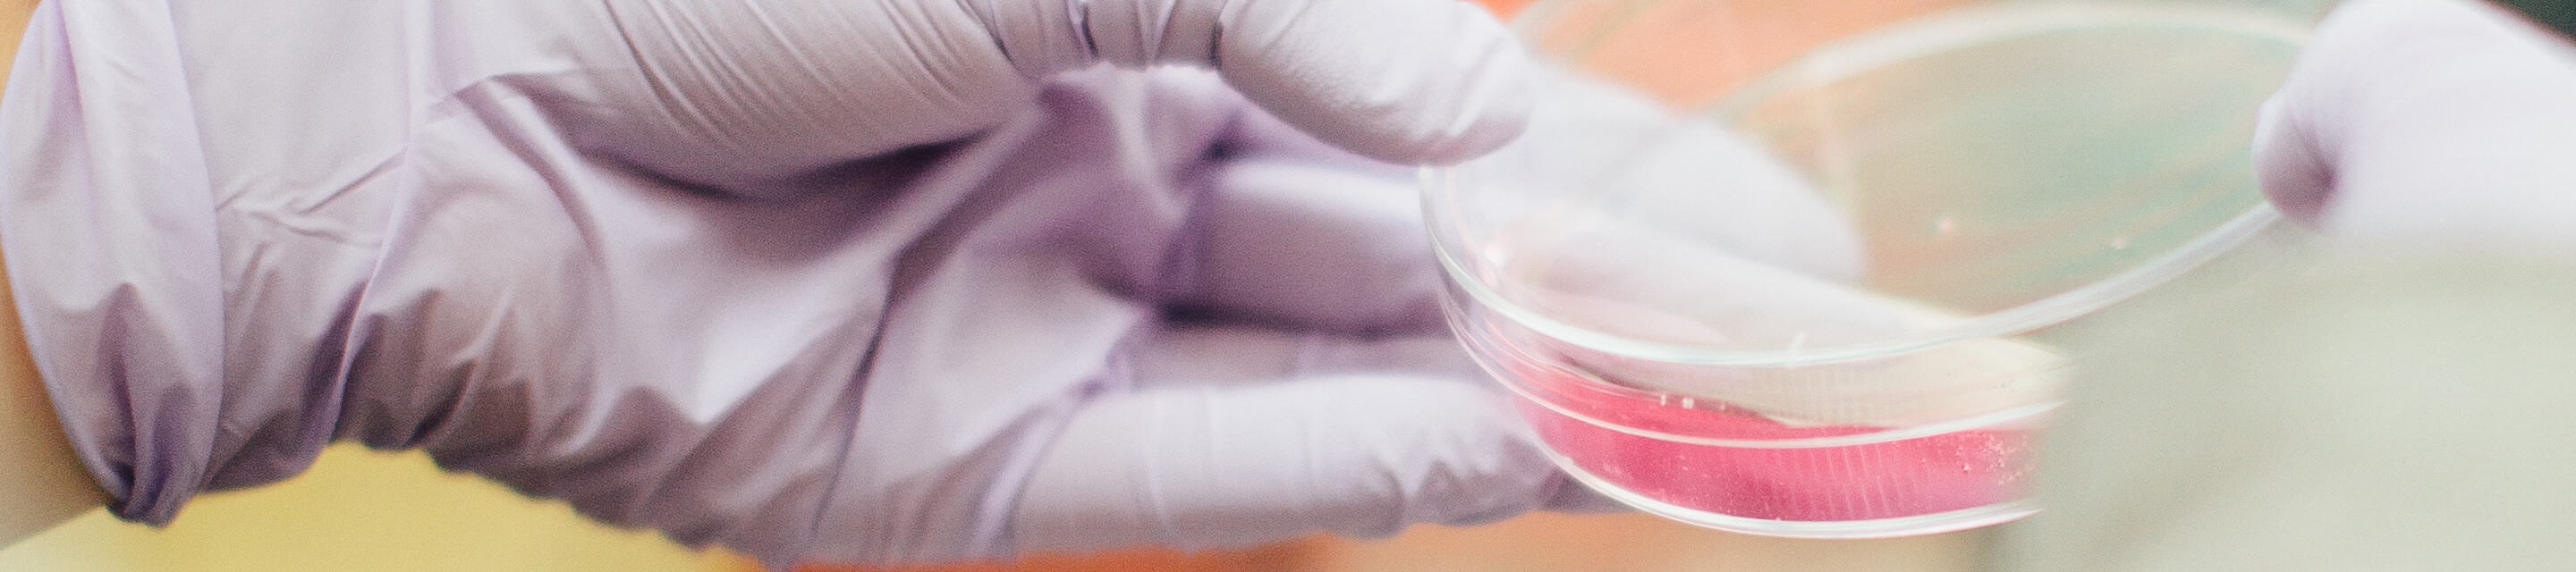
Hand holding a petri dish

Research, powered by deep analytics.
At the heart of the Chronic Condition Warehouse is the VRDC: Virtual Research Data Center. The VRDC provides powerful analytic tools and allows authorized contractors and researchers to access and analyze the healthcare data virtually and securely. Integrating seamlessly with CMS’s own website, the service allows users to quickly assess their cohorts. Improving workflow, reducing costs, deepening insights.